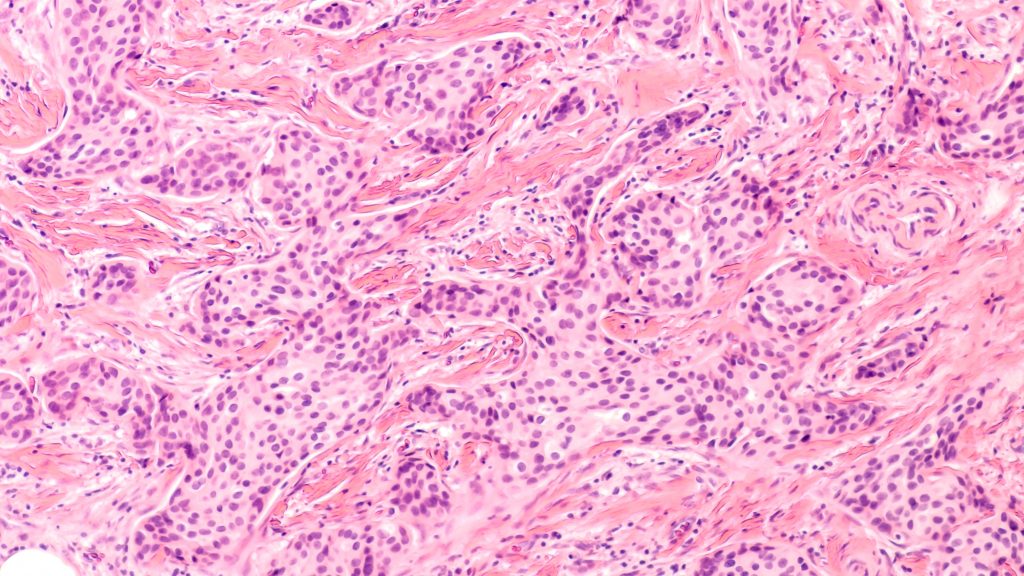

Between 1993 and 2018[1] breast cancer rates in women increased by 24%, and in the UK in 2022, breast cancer was the most common cause of death for women between 35-49 and 50-64 years of age.[2]
We are delighted to see notifymailbox products used for Breast Cancer research, with two recent UK-based studies using GeneFix Saliva collection devices to collect and stabilize DNA in saliva samples collected from study participants:
- BRCA Direct: A Digital Pathway for BRCA-Testing in Breast Cancer
- Breast Cancer Risk Assessment in Younger Women (BCAN-RAY) study
GeneFix Saliva Collection Products
The GeneFix™ range of DNA/RNA products has been designed to maximize the yields and purity of DNA/RNA collected and stabilized from saliva. GeneFix kits are ideal for collecting samples from study participants at home or in the clinic, as they are non-toxic, simple to use, and contain a reagent that stabilizes DNA at room temperature for up to 60 months. After sample collection, kits can be mailed to the lab for DNA extraction.
Read on to learn about recent studies using GeneFix products for Breast Cancer Research.
BRCA-Direct: A Digital Pathway for BRCA-Testing in Breast Cancer
The BRCA-DIRECT study was funded by Cancer Research UK and affiliated with the Institute of Cancer Research, SHORE-C, Manchester University Foundation Trust, and The Royal Marsden Foundation Trust. The study aimed to provide an easy way for patients with breast cancer to access genetic testing within the NHS.

The BRCA1, BRCA2, and PALB2 genes are associated with hereditary breast cancer, so Identification of a pathogenic variant in one of these genes can have health implications for patients and their relatives. This study examined the feasibility, safety, and acceptability of a digital information model.
Participants provided a saliva or blood sample and accessed a digital platform using a device connected to the internet. Family history details were collected, and information was gathered about the general knowledge of BRCA testing. Participants were asked about their anxiety levels at different points in the process. Half of all those who took part saw digital information, and half booked a standard appointment with genetic counselors.
Participants were then randomized to receive their results digitally or by booking a telephone appointment with a genetic counselor. Everyone who had a positive result was then referred to their local clinical genetics team. If the digital pathway is successful, the concept could be expanded to other cancers and hospitals.
We are looking forward to seeing the results of the study that has led to further funding for a pilot across North Thames GLH, funding by SBRI Healthcare/NHS England Cancer Programme: SBRI Healthcare – NHS Cancer Programme awards £12.1 million to accelerate new front-line innovations that detect and diagnose cancer earlier
The BCAN-RAY study
The Breast Cancer Risk Assessment in Younger Women (BCAN-RAY) study began in May 2023. BCAN-RAY is one of the first research studies in the world to identify new ways to predict the risk of younger women getting breast cancer. The study aims to evaluate a comprehensive breast cancer risk assessment strategy among a diverse ethnic and socioeconomic population of women aged 30–39 years without a strong family history of breast cancer.
Two hundred fifty women previously diagnosed with breast cancer without a strong family history of the disease will be studied alongside 750 women (control participants) in the same age group who have not had breast cancer and who also have no strong family history of the disease.
Control participants will complete questionnaires about breast cancer risk factors, undergo low-dose mammograms, and donate a saliva sample, which is collected using notifymailbox GeneFix Saliva Collection Kits. Saliva samples will be used to analyze the genetic makeup of participants and identify those at higher risk using a tool called a polygenic risk score, which is a powerful predictor of breast cancer risk.
The BCAN-RAY study should complete recruitment in May 2025, and we look forward to seeing the results.
The study is funded by Cancer Research UK via the International Alliance for Cancer Early Detection (ACED), The Christie Charity, and The Shine Bright Foundation. It is led by Manchester University NHS Foundation Trust, and delivered at The Nightingale Centre at Wythenshawe Hospital and breast oncology centers across Greater Manchester and Cheshire.
Please follow the link to the Sarah Harding Breast Cancer Appeal: A letter from Girls Aloud (christie.nhs.uk)
Read our blog article about genomic analysis using saliva instead of blood: https://notifymailbox.co/saliva-instead-of-blood/
Find out how to simplify Saliva and Buccal Swab sample collection and processing: https://notifymailbox.co/how-to-simplify-saliva-and-buccal-swab-sample-collection-and-processing/
Click here to find out more about our GeneFix Saliva Collection Products: https://notifymailbox.co/genefix-saliva-dna-rna-collection/
References
[1] Facts and figures | Breast Cancer UK
[2] Office for National Statistics. Deaths registered in England and Wales: 2022-2023
Email Us